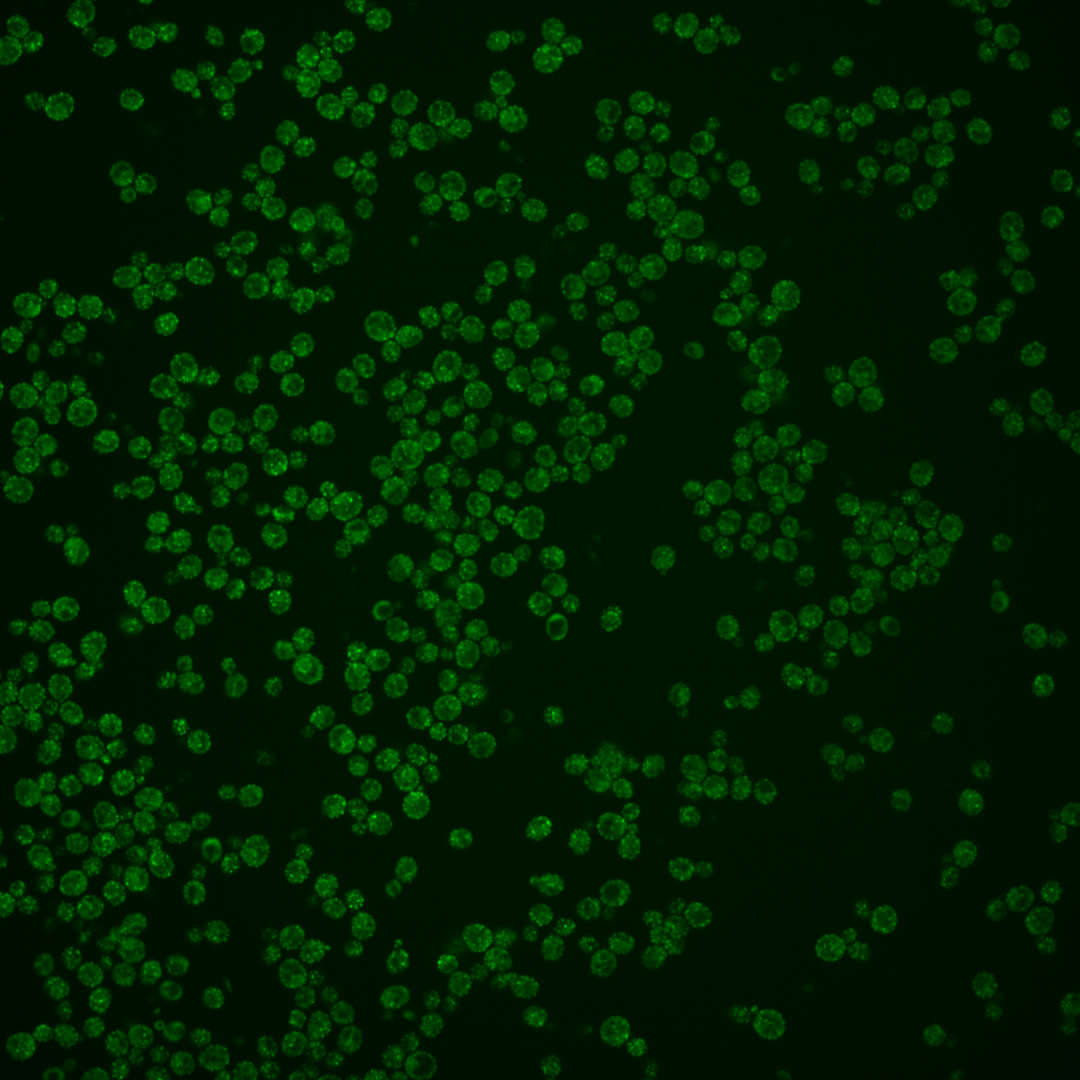
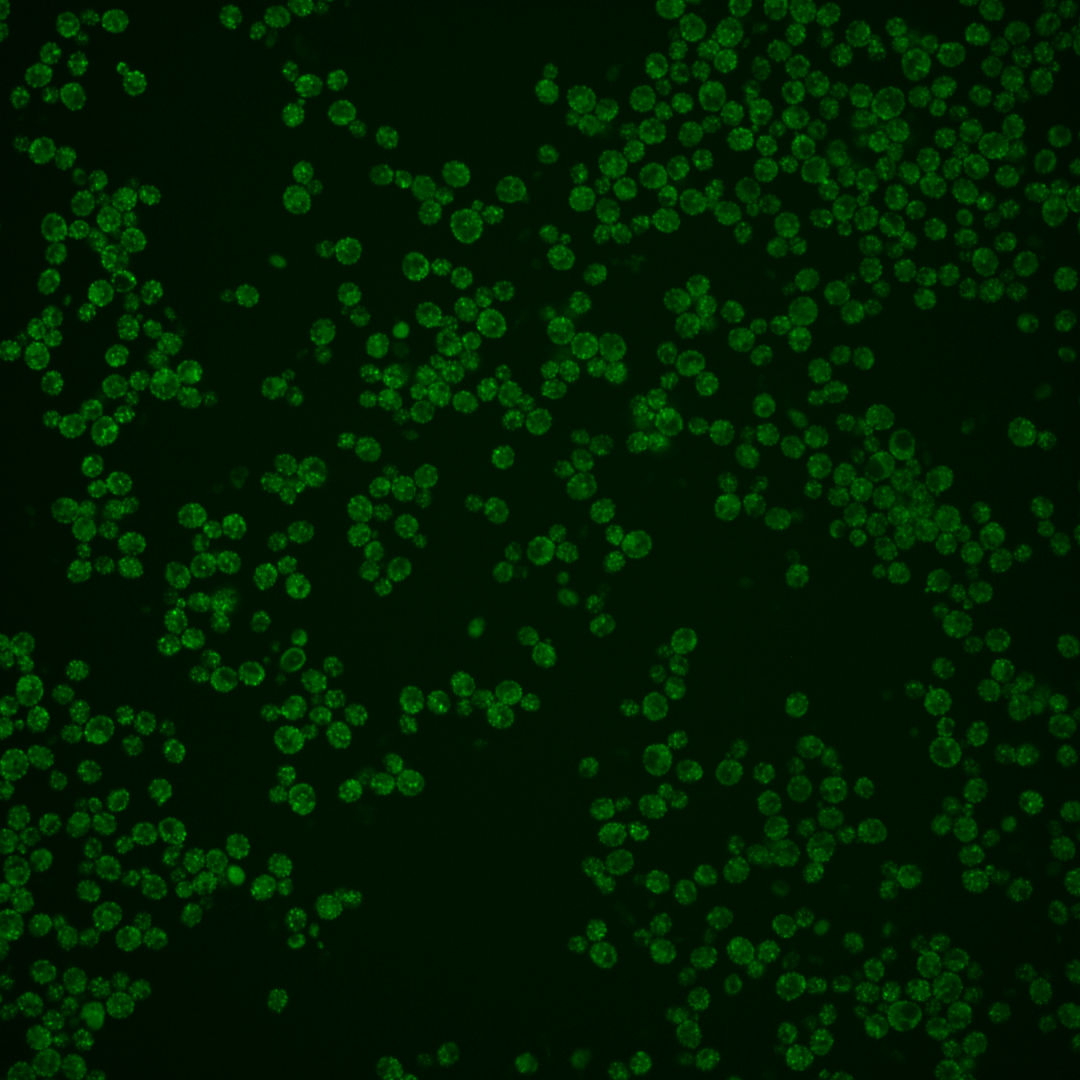
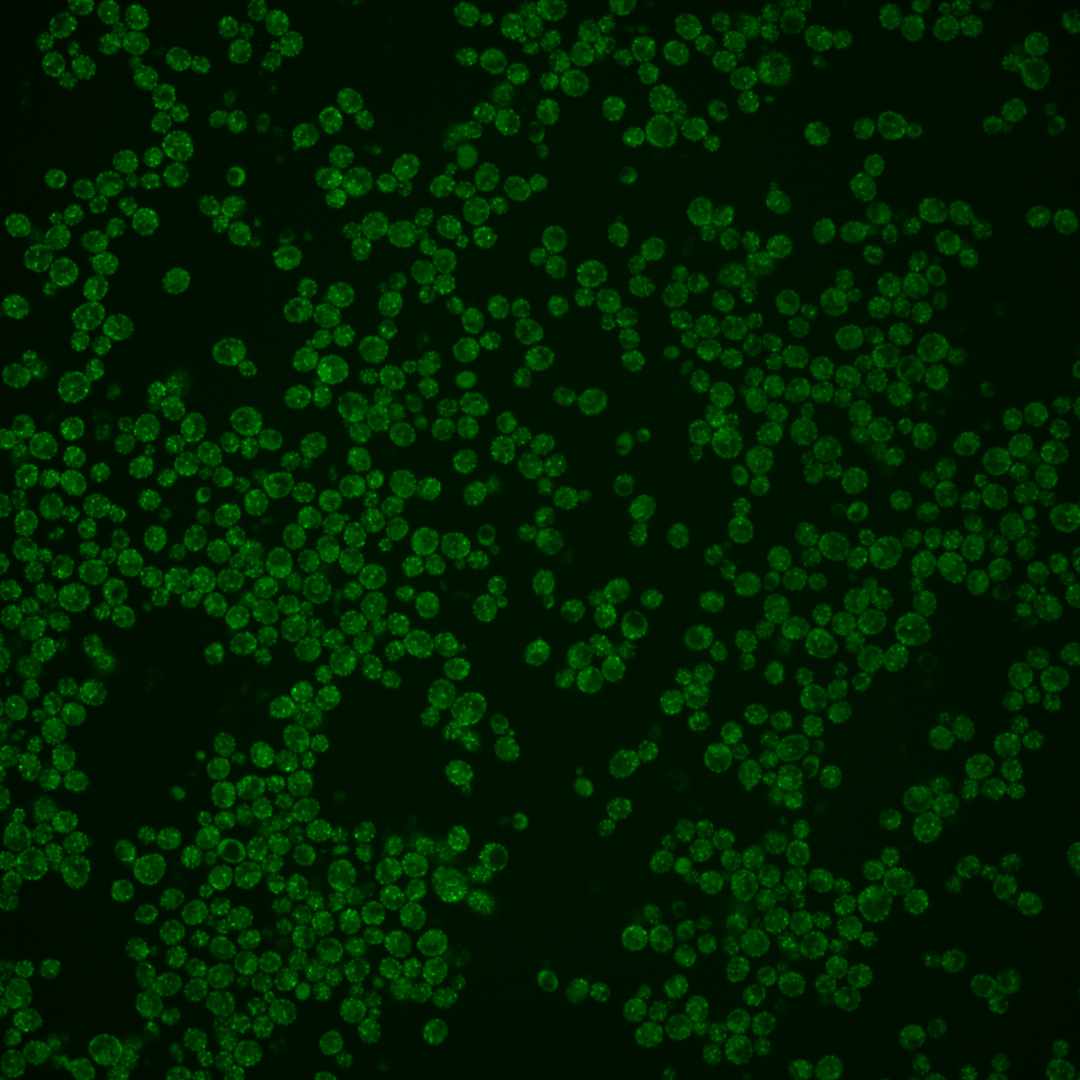

| Standard name | |
|---|---|
| Human Ortholog | |
| Description | COPII vesicle coat protein required for ER transport vesicle budding; essential factor in endoplasmic reticulum exit site (ERES) formation, as well as in COPII-mediated ER-to-Golgi traffic; bound to periphery of ER membranes and may act to stabilize initial COPII complexes; interacts with Sec23p, Sec24p and Sec31p |
Micrographs




















































































Sub-cellular Localization
Yeast GFP Assignment
Protein Abundance
Localization Change
External localization resources
| ensLOC | DeepLoc | |||||||||||||||||||||||
|---|---|---|---|---|---|---|---|---|---|---|---|---|---|---|---|---|---|---|---|---|---|---|---|---|
| Localization | WT1 | WT2 | WT3 | RAP60 | RAP140 | RAP220 | RAP300 | RAP380 | RAP460 | RAP540 | RAP620 | RAP700 | HU80 | HU120 | HU160 | rpd3Δ_1 | rpd3Δ_2 | rpd3Δ_3 | WT1 | WT2 | WT3 | AF100 | AF140 | AF180 |
| Cortical Patches | 189 | 111 | 285 | 199 | 210 | 261 | 173 | 147 | 123 | 100 | 56 | 97 | 99 | 126 | 117 | 54 | 43 | 53 | 171 | 85 | 270 | 73 | 129 | 100 |
| Bud | 11 | 10 | 63 | 47 | 66 | 53 | 101 | 71 | 48 | 54 | 56 | 60 | 9 | 11 | 22 | 0 | 1 | 1 | 0 | 0 | 0 | 0 | 0 | 0 |
| Bud Neck | 0 | 0 | 0 | 0 | 0 | 0 | 0 | 0 | 0 | 0 | 0 | 1 | 0 | 0 | 0 | 0 | 0 | 0 | 0 | 0 | 0 | 0 | 0 | 0 |
| Bud Site | 0 | 0 | 0 | 0 | 0 | 1 | 1 | 1 | 1 | 7 | 1 | 1 | 0 | 0 | 0 | 0 | 0 | 0 | – | – | – | – | – | – |
| Cell Periphery | 14 | 13 | 40 | 44 | 42 | 49 | 31 | 21 | 21 | 36 | 22 | 37 | 16 | 9 | 17 | 11 | 10 | 14 | 2 | 2 | 13 | 2 | 5 | 7 |
| Cytoplasm | 9 | 37 | 31 | 24 | 23 | 35 | 48 | 29 | 27 | 34 | 19 | 21 | 18 | 23 | 17 | 12 | 15 | 20 | 2 | 6 | 2 | 3 | 0 | 0 |
| Endoplasmic Reticulum | 149 | 210 | 195 | 109 | 130 | 236 | 139 | 153 | 136 | 110 | 98 | 111 | 124 | 132 | 117 | 11 | 7 | 4 | 104 | 112 | 97 | 39 | 44 | 52 |
| Endosome | 9 | 3 | 15 | 0 | 16 | 5 | 23 | 21 | 2 | 2 | 0 | 2 | 1 | 1 | 3 | 3 | 1 | 0 | 6 | 6 | 8 | 1 | 1 | 1 |
| Golgi | 207 | 18 | 41 | 9 | 25 | 5 | 6 | 1 | 3 | 2 | 3 | 3 | 49 | 78 | 43 | 88 | 71 | 79 | 71 | 51 | 97 | 15 | 22 | 23 |
| Mitochondria | 21 | 19 | 126 | 227 | 183 | 358 | 496 | 576 | 502 | 546 | 415 | 611 | 5 | 28 | 88 | 6 | 9 | 10 | 4 | 12 | 28 | 6 | 4 | 2 |
| Nucleus | 0 | 0 | 0 | 0 | 0 | 1 | 0 | 0 | 3 | 1 | 1 | 0 | 3 | 0 | 0 | 0 | 0 | 0 | 0 | 0 | 0 | 0 | 0 | 0 |
| Nuclear Periphery | 0 | 1 | 0 | 0 | 0 | 3 | 0 | 2 | 1 | 2 | 3 | 2 | 1 | 0 | 4 | 1 | 0 | 0 | 0 | 1 | 0 | 0 | 0 | 0 |
| Nucleolus | 0 | 0 | 0 | 0 | 0 | 0 | 0 | 1 | 0 | 1 | 1 | 1 | 0 | 0 | 0 | 0 | 0 | 0 | 0 | 0 | 0 | 0 | 0 | 0 |
| Peroxisomes | 1 | 0 | 26 | 4 | 52 | 16 | 40 | 41 | 12 | 38 | 18 | 24 | 3 | 5 | 5 | 1 | 0 | 1 | 3 | 1 | 17 | 0 | 1 | 0 |
| SpindlePole | 0 | 0 | 0 | 0 | 4 | 0 | 4 | 3 | 1 | 6 | 7 | 2 | 0 | 1 | 0 | 0 | 0 | 1 | 0 | 0 | 0 | 0 | 0 | 0 |
| Vac/Vac Membrane | 4 | 1 | 2 | 0 | 2 | 1 | 3 | 18 | 0 | 2 | 1 | 2 | 0 | 1 | 1 | 1 | 3 | 2 | 0 | 5 | 2 | 2 | 0 | 0 |
| Unique Cell Count | 333 | 281 | 476 | 367 | 433 | 603 | 691 | 762 | 607 | 656 | 490 | 702 | 194 | 254 | 262 | 119 | 106 | 118 | 369 | 293 | 546 | 149 | 214 | 193 |
| Labelled Cell Count | 614 | 423 | 824 | 663 | 753 | 1024 | 1065 | 1085 | 880 | 941 | 701 | 975 | 328 | 415 | 434 | 188 | 160 | 185 | 369 | 293 | 546 | 149 | 214 | 193 |
Yeast GFP Assignment
Protein Abundance
| Screen | WT1 | WT2 | WT3 | RAP60 | RAP140 | RAP220 | RAP300 | RAP380 | RAP460 | RAP540 | RAP620 | RAP700 | HU80 | HU120 | HU160 | rpd3Δ_1 | rpd3Δ_2 | rpd3Δ_3 | AF100 | AF140 | AF180 |
|---|---|---|---|---|---|---|---|---|---|---|---|---|---|---|---|---|---|---|---|---|---|
| Mean Cell GFP Intensity (1e-4) | 12.6 | 10.3 | 7.6 | 6.8 | 7.2 | 6.3 | 6.0 | 5.9 | 5.3 | 5.2 | 4.9 | 4.8 | 10.6 | 10.4 | 9.3 | 12.1 | 14.0 | 13.0 | 10.9 | 12.1 | 12.4 |
| Std Deviation (1e-4) | 1.9 | 1.7 | 1.0 | 1.1 | 1.0 | 0.9 | 0.9 | 1.0 | 1.0 | 1.0 | 0.9 | 0.9 | 1.7 | 1.9 | 1.6 | 3.0 | 2.5 | 2.6 | 2.2 | 2.0 | 2.1 |
| Intensity Change (Log2) | – | – | – | -0.15 | -0.07 | -0.26 | -0.33 | -0.35 | -0.52 | -0.54 | -0.62 | -0.65 | 0.48 | 0.46 | 0.31 | 0.68 | 0.89 | 0.79 | 0.52 | 0.68 | 0.71 |
Localization Change
| Localization | RAP60 | RAP140 | RAP220 | RAP300 | RAP380 | RAP460 | RAP540 | RAP620 | RAP700 | HU80 | HU120 | HU160 | rpd3Δ_1 | rpd3Δ_2 | rpd3Δ_3 |
|---|---|---|---|---|---|---|---|---|---|---|---|---|---|---|---|
| Cortical Patches | -1.6 | -3.4 | -5.4 | -12.0 | -14.6 | -13.4 | -15.6 | -15.8 | 0 | -2.1 | -2.7 | -4.0 | -2.9 | -3.6 | -2.9 |
| Bud | -0.2 | 0.9 | -2.3 | 0.7 | -2.2 | -2.9 | -2.7 | -0.9 | 0 | -3.3 | -3.8 | -2.0 | -4.2 | -3.7 | -3.9 |
| Bud Neck | 0 | 0 | 0 | 0 | 0 | 0 | 0 | 0 | 0 | 0 | 0 | 0 | 0 | 0 | 0 |
| Bud Site | 0 | 0 | 0 | 0 | 0 | 0 | 0 | 0 | 0 | 0 | 0 | 0 | 0 | 0 | 0 |
| Cell Periphery | 1.7 | 0.7 | -0.2 | -2.8 | -4.5 | -3.5 | -1.9 | -2.5 | 0 | -0.1 | -2.5 | -0.9 | 0.3 | 0.3 | 1.2 |
| Cytoplasm | 0 | -0.8 | -0.5 | 0.3 | -2.2 | -1.5 | -0.9 | -1.8 | -2.9 | 1.2 | 1.3 | 0 | 1.3 | 2.6 | 3.6 |
| Endoplasmic Reticulum | -3.4 | -3.4 | -0.6 | -7.7 | -8.0 | -6.6 | -9.1 | -7.1 | 0 | 5.4 | 2.8 | 1.0 | -6.5 | -6.7 | -7.7 |
| Endosome | -3.4 | 0.5 | -2.8 | 0.2 | -0.4 | -3.7 | -3.9 | -4.0 | 0 | 0 | -2.4 | -1.7 | 0 | 0 | 0 |
| Golgi | -3.8 | -1.6 | -6.3 | -6.6 | -8.0 | -6.7 | -7.2 | -6.0 | 0 | 5.7 | 7.7 | 3.2 | 15.5 | 13.8 | 14.1 |
| Mitochondria | 10.3 | 5.0 | 10.8 | 15.2 | 17.0 | 18.6 | 19.2 | 18.2 | 0 | -7.1 | -4.9 | 2.0 | -5.0 | -4.0 | -4.2 |
| Nucleus | 0 | 0 | 0 | 0 | 0 | 0 | 0 | 0 | 0 | 0 | 0 | 0 | 0 | 0 | 0 |
| Nuclear Periphery | 0 | 0 | 0 | 0 | 0 | 0 | 0 | 0 | 0 | 0 | 0 | 0 | 0 | 0 | 0 |
| Nucleolus | 0 | 0 | 0 | 0 | 0 | 0 | 0 | 0 | 0 | 0 | 0 | 0 | 0 | 0 | 0 |
| Peroxisomes | -3.4 | 3.5 | -2.4 | 0.2 | -0.1 | -3.1 | 0.2 | -1.3 | 0 | -2.3 | -2.2 | -2.3 | -2.2 | 0 | -2.2 |
| SpindlePole | 0 | 0 | 0 | 0 | 0 | 0 | 0 | 0 | 0 | 0 | 0 | 0 | 0 | 0 | 0 |
| Vacuole | 0 | 0 | 0 | 0 | 2.6 | 0 | 0 | 0 | 0 | 0 | 0 | 0 | 0 | 0 | 0 |
External localization resources
Images






























Protein Concentration and Protein Localization Data
| R1 | R2 | R3 | ||||||||||||||||
|---|---|---|---|---|---|---|---|---|---|---|---|---|---|---|---|---|---|---|
| G1 Pre-START | G1 Post-START | S/G2 | Metaphase | Anaphase | Telophase | G1 Pre-START | G1 Post-START | S/G2 | Metaphase | Anaphase | Telophase | G1 Pre-START | G1 Post-START | S/G2 | Metaphase | Anaphase | Telophase | |
| Concentration | 6.5791 | 8.7948 | 7.9992 | 6.842 | 7.6838 | 8.1845 | 8.8559 | 11.4853 | 10.374 | 9.0988 | 9.5807 | 10.4539 | 10.8078 | 11.8212 | 11.0547 | 10.8076 | 11.0423 | 11.2234 |
| Actin | 0.2528 | 0.2018 | 0.1973 | 0.2067 | 0.0788 | 0.3162 | 0.202 | 0.2873 | 0.235 | 0.2415 | 0.169 | 0.2004 | 0.1431 | 0.1901 | 0.1943 | 0.1294 | 0.3093 | 0.2294 |
| Bud | 0.0006 | 0.0003 | 0.0006 | 0.0007 | 0.0024 | 0.0003 | 0.0005 | 0.0029 | 0.0005 | 0.0003 | 0.0001 | 0.0002 | 0.0002 | 0.0002 | 0.0001 | 0.0001 | 0.0002 | 0.0003 |
| Bud Neck | 0.0081 | 0.0019 | 0.0021 | 0.0029 | 0.0012 | 0.0076 | 0.0084 | 0.0021 | 0.0015 | 0.0011 | 0.0014 | 0.0033 | 0.001 | 0.0014 | 0.0015 | 0.0021 | 0.0039 | 0.0031 |
| Bud Periphery | 0.0008 | 0.0003 | 0.0015 | 0.0011 | 0.0024 | 0.0004 | 0.0005 | 0.0007 | 0.0004 | 0.0003 | 0.0002 | 0.0003 | 0.0004 | 0.0002 | 0.0002 | 0.0001 | 0.0007 | 0.0005 |
| Bud Site | 0.0134 | 0.0033 | 0.0035 | 0.0015 | 0.0052 | 0.0006 | 0.0107 | 0.0186 | 0.0055 | 0.0004 | 0.0003 | 0.0002 | 0.0012 | 0.0007 | 0.0004 | 0.0002 | 0.0007 | 0.0033 |
| Cell Periphery | 0.0013 | 0.002 | 0.0018 | 0.0033 | 0.0006 | 0.0013 | 0.0011 | 0.001 | 0.0009 | 0.0015 | 0.0006 | 0.0013 | 0.0008 | 0.0012 | 0.0014 | 0.0027 | 0.0021 | 0.0012 |
| Cytoplasm | 0.0234 | 0.024 | 0.0147 | 0.004 | 0.0027 | 0.0065 | 0.0085 | 0.0269 | 0.0128 | 0.0047 | 0.006 | 0.007 | 0.0032 | 0.0097 | 0.0079 | 0.0067 | 0.0037 | 0.0113 |
| Cytoplasmic Foci | 0.029 | 0.0431 | 0.0311 | 0.0296 | 0.0156 | 0.0232 | 0.0392 | 0.0465 | 0.034 | 0.0294 | 0.026 | 0.0263 | 0.0251 | 0.025 | 0.0159 | 0.0257 | 0.018 | 0.0178 |
| Eisosomes | 0.0025 | 0.0033 | 0.0013 | 0.0036 | 0.0004 | 0.002 | 0.0022 | 0.0009 | 0.002 | 0.0024 | 0.0011 | 0.0047 | 0.003 | 0.0036 | 0.0113 | 0.0068 | 0.0169 | 0.0064 |
| Endoplasmic Reticulum | 0.0268 | 0.0329 | 0.0287 | 0.0138 | 0.0145 | 0.0144 | 0.0162 | 0.0244 | 0.0078 | 0.0141 | 0.0348 | 0.0355 | 0.005 | 0.0114 | 0.008 | 0.0432 | 0.0073 | 0.0199 |
| Endosome | 0.0576 | 0.0546 | 0.0508 | 0.0867 | 0.039 | 0.077 | 0.05 | 0.047 | 0.0308 | 0.0376 | 0.0686 | 0.0461 | 0.0402 | 0.0274 | 0.0231 | 0.0273 | 0.0228 | 0.0281 |
| Golgi | 0.4917 | 0.5802 | 0.6098 | 0.5491 | 0.7522 | 0.5105 | 0.5754 | 0.5212 | 0.6394 | 0.5947 | 0.662 | 0.6432 | 0.7333 | 0.7177 | 0.7191 | 0.7183 | 0.6053 | 0.6621 |
| Lipid Particles | 0.0564 | 0.0477 | 0.0391 | 0.0265 | 0.0667 | 0.0323 | 0.0189 | 0.0164 | 0.0147 | 0.0595 | 0.0195 | 0.0184 | 0.0203 | 0.0084 | 0.0132 | 0.0122 | 0.0043 | 0.0068 |
| Mitochondria | 0.0098 | 0.0013 | 0.0074 | 0.0623 | 0.0136 | 0.0022 | 0.0066 | 0.0014 | 0.0024 | 0.0052 | 0.0055 | 0.0077 | 0.0092 | 0.0015 | 0.0015 | 0.0041 | 0.0035 | 0.007 |
| None | 0.0046 | 0.0002 | 0.001 | 0.0004 | 0.0002 | 0.0001 | 0.0054 | 0.0002 | 0.0002 | 0.0003 | 0.0002 | 0.0003 | 0.0021 | 0.0001 | 0.0001 | 0.0002 | 0.0002 | 0.0004 |
| Nuclear Periphery | 0.0032 | 0.0006 | 0.0013 | 0.0012 | 0.0009 | 0.0005 | 0.0058 | 0.0003 | 0.0002 | 0.0003 | 0.0003 | 0.0007 | 0.001 | 0.0002 | 0.0002 | 0.0001 | 0.0002 | 0.0003 |
| Nucleolus | 0.0006 | 0 | 0.0001 | 0.0001 | 0.0001 | 0 | 0.0166 | 0 | 0 | 0 | 0 | 0 | 0.0004 | 0 | 0 | 0 | 0 | 0 |
| Nucleus | 0.0055 | 0.0001 | 0.0003 | 0.0002 | 0.0004 | 0.0001 | 0.0146 | 0.0001 | 0 | 0 | 0.0001 | 0.0001 | 0.0003 | 0 | 0 | 0 | 0 | 0.0001 |
| Peroxisomes | 0.0064 | 0.001 | 0.005 | 0.0026 | 0.0013 | 0.0027 | 0.0042 | 0.0011 | 0.0112 | 0.0057 | 0.0018 | 0.0034 | 0.0071 | 0.0006 | 0.0011 | 0.0202 | 0.0006 | 0.0011 |
| Punctate Nuclear | 0.0027 | 0.0002 | 0.0004 | 0.0005 | 0.0003 | 0.0002 | 0.0111 | 0.0002 | 0.0003 | 0.0003 | 0.0001 | 0.0002 | 0.001 | 0.0001 | 0.0001 | 0.0001 | 0.0001 | 0.0001 |
| Vacuole | 0.0015 | 0.0006 | 0.0014 | 0.0016 | 0.0007 | 0.0009 | 0.0011 | 0.0004 | 0.0002 | 0.0004 | 0.0012 | 0.0004 | 0.0013 | 0.0002 | 0.0002 | 0.0002 | 0.0002 | 0.0003 |
| Vacuole Periphery | 0.0013 | 0.0005 | 0.0008 | 0.0018 | 0.0009 | 0.0009 | 0.0011 | 0.0003 | 0.0002 | 0.0004 | 0.0014 | 0.0006 | 0.0008 | 0.0002 | 0.0003 | 0.0002 | 0.0002 | 0.0004 |
Sequencing Data
| R1 | R2 | |||||||||
|---|---|---|---|---|---|---|---|---|---|---|
| G1 Post-START | S/G2 | Metaphase | Anaphase | Telophase | G1 Post-START | S/G2 | Metaphase | Anaphase | Telophase | |
| Gene Expression | 49.2412 | 47.0131 | 55.3283 | 58.6992 | 45.6024 | 45.0291 | 57.0721 | 58.6993 | 48.9609 | 55.2699 |
| Translational Efficiency | 1.8038 | 1.7512 | 1.3619 | 1.1771 | 1.4576 | 1.6381 | 1.1259 | 1.1045 | 1.2582 | 1.1494 |
Hit Data
| Dataset | Hit |
|---|---|
| Protein Concentration | ✘ |
| Protein Localization | ✘ |
| Gene Expression | ✔ |
| Translational Efficiency | ✘ |
Endocytosis
| Temp | Actin Patch (Sac6-tdTomato) | Cortical Patch (Sla1-GFP) | Late Endosome (Snf7-GFP) | Vacuole (Vph1-GFP) |
|---|---|---|---|---|
| 37℃ | ||||
| RT |
Cell Cycle Omics
CYCLoPs (Sec16-GFP)
| Gene / Allele | Actin Patch (Sac6-tdTomato) | Cortical Patch (Sla1-GFP) | Late Endosome (Snf7-GFP) | Vacuole (Sac6-tdTomato) |
|---|
| Gene | Images |
|---|
| Gene | Images |
|---|
Images are not yet available
Images are not yet available